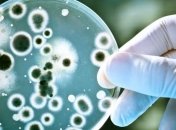
Ученым удалось создать живые сенсоры из бактерий

Новости по теме Сенсор
-

Две новые модели начнут массово производиться уже во второй половине 2019 года.
-

В Гарварде разработали датчик для детей, который на ранней стадии определит нарушения в развитии.
-

Добавить громкости в плеере, или ответить на телефонный звонок, просто ткнув пальцем в ладонь, – теперь это не кажется такой уж фантастикой.
-

Компания Sony представила свою новую модель компактной фотокамеры RX100 VI.
-

Эта новая разработка — очередной шаг на пути к созданию гибких гаджетов.
-
Ученые-биологи смогли создать новый необычный "живой материал-сенсор" из бактерий.
-

Ученые из США сконструировали сенсор, позволяющий измерять концентрацию молекул в крови бодрствующего животного в режиме реального времени.
-

В Японии создали котоперчатки для смартфонов, которые позволяют пользоваться смартфонами, не открывая рук на морозе.
-

Признаком проблемы является серая мигающая полоса в верхней части экрана iPhone 6/6 Plus.
-

На рынке появятся смартфоны Nokia, оснащенные камерой с уникальным сенсором.
-

Крупногабаритные смартфоны крайне неудобны в использование одной рукой, но изобретение японских производителей поможет решить эту проблему.
-

Представлен смартфон Huawei Honor 7i с поворотным модулем камеры и сканером отпечатков на боковой грани.
-

У пользователей с татуировками на руке возникают проблемы при работе со смарт-часами.
-

BlackBerry представила смартфон с полностью сенсорным управлением.
-

Генеральный директор Swatch Ник Хайек озвучил планы компании по производству линейки "умных" часов.
-

Современные смартфоны, как правило, разряжаются гораздо быстрее, чем хотелось бы их владельцам.


